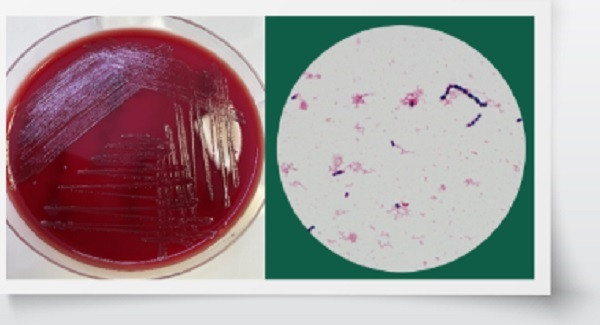
TP.HCM: Một người đàn ông nhiễm vi khuẩn liên cầu lợn - Ảnh 1. Phương pháp chẩn đoán vi sinh liên cầu lợn. Ảnh: BSCC

Ngày 20.9, thông tin từ Bệnh viện Quân y 175 cho biết, bệnh viện vừa phát hiện một mẫu dịch não tủy của bệnh nhân nam 59 tuổi gửi từ Khoa Truyền nhiễm; dịch đục, bạch cầu tăng, protein tăng.
Theo bác sĩ Nguyễn Thị Trang (Khoa Vi sinh, Bệnh viện Quân y 175), kết quả nhuộm soi có hình ảnh cầu khuẩn Gram dương, đứng riêng lẻ, đứng đôi, chuỗi ngắn, kết quả nuôi cấy và định danh là Streptococcus suis (liên cầu lợn).
Khai thác bệnh sử được biết, 10 ngày trước bệnh nhân sốt, đau mỏi toàn thân, điều trị tại bệnh viện tuyến dưới và được chẩn đoán nhiễm vi rút cấp, bệnh ổn định và ra viện.
Sau đó 3 ngày, bệnh nhân sốt lại, kèm lạnh run, đau đầu ít, sau đó đau đầu dữ dội, không nôn, tự dùng thuốc giảm đau không đỡ, xuất hiện tình trạng kích thích, la hét và đã tiến hành nhập viện tại Khoa Truyền nhiễm, Bệnh viện Quân y 175.
Tại đây, bệnh nhân được chẩn đoán theo dõi viêm màng não mủ trên bệnh nhân tăng huyết áp, đái tháo đường loại 2, gout mạn. Bệnh nhân được chỉ định thực hiện các xét nghiệm cận lâm sàng, trong đó có xét nghiệm chọc dịch não tủy và gửi Khoa Vi sinh nuôi cấy. Kết quả cấy khuẩn mọc Streptococcus suis (liên cầu lợn) đã kịp thời hỗ trợ các bác sĩ lâm sàng trong việc lựa chọn kháng sinh điều trị.
Các bác sĩ đánh giá yếu tố nguy cơ gây ra bệnh được chẩn đoán là do người bệnh chăn nuôi lợn và mổ lợn trước khi khởi phát bệnh 2 tuần.
![]() |
| Phương pháp chẩn đoán vi sinh liên cầu lợn. Ảnh: BSCC |
Nguyên nhân và triệu chứng liên cầu lợn
Theo bác sĩ Trang, liên cầu lợn là vi khuẩn cư trú ở đường hô hấp trên (mũi, họng), đường sinh dục và tiêu hóa của lợn gây nhiễm trùng nặng ở lợn và có khả năng lây lan cho người. Đường lây chủ yếu do tiếp xúc, do sử dụng các chế phẩm từ thịt lợn thiếu an toàn như những người có vết thương nhỏ, hoặc trầy xước trên da trong quá trình tiếp xúc trực tiếp với lợn mang vi khuẩn, giết mổ, chế biến thịt lợn và quá trình chăn nuôi lợn rất dễ bị nhiễm liên cầu lợn.
Những người ăn các sản phẩm từ thịt lợn chưa được nấu chín như tiết canh, gỏi, nem, nội tạng của lợn nhiễm liên cầu cũng rất dễ bị nhiễm liên cầu lợn. Tuy nhiên chưa có bằng chứng lây nhiễm liên cầu lợn từ người sang người.
Thời gian ủ bệnh ngắn từ vài giờ cho đến 2-3 ngày, có trường hợp ủ bệnh lên đến vài tuần. Bệnh cảnh phổ biến nhất là viêm màng não với các triệu chứng sốt cao, đau đầu, buồn nôn, nôn, ù tai, điếc, gáy cứng, rối loạn tri giác, xuất huyết dưới da dạng chấm, mảng ở vành tai, mũi, mặt, thân mình…, dịch não tủy đục, áp lực tăng, tăng bạch cầu và protein. Trường hợp nặng gây nhiễm trùng huyết, sốc nhiễm khuẩn, rối loạn đông máu nặng, suy đa tạng, xuất huyết tiêu hóa, hôn mê, tử vong nhanh.
Cách phòng bệnh liên cầu lợn
Theo bác sĩ Trang, hiện chưa có vắc xin phòng bệnh. Để phòng liên cầu lợn, người dân nên chọn mua thịt lợn đã qua kiểm định của cơ quan thú y, tránh mua thịt lợn có màu đỏ khác thường, xuất huyết hoặc phù nề. Không ăn lợn chết, lợn tái, đặc biệt là tiết canh lợn trong thời gian có dịch. Những người có vết thương hở phải đeo găng tay khi tiếp xúc với thịt lợn tái hoặc sống.
Phải giữ các dụng cụ chế biến ở nơi sạch sẽ, dùng riêng cho thịt sống và thịt chín. Rửa sạch tay và các dụng cụ chế biến sau khi tiếp xúc, chế biến thịt lợn. Không giết mổ, vận chuyển lợn bệnh, lợn chết phải tiêu hủy đúng cách. Lợn ốm, chết phải chôn, đổ thuốc sát khuẩn và tiêu hủy. Chuồng trại và môi trường chăn nuôi phải phun thuốc sát khuẩn, khử khuẩn.